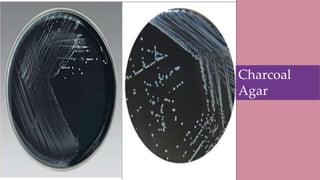
Diagnosis
• Gram staining and microscopy
•Oxidase Test
•Immunoassay Test
•Culture
Arrow shows
C. jejuni
Charcoal
Agar
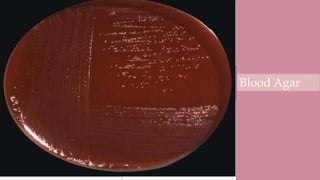
Diagnosis
• Gram staining and microscopy
•Oxidase Test
•Immunoassay Test
•Culture
Arrow shows
C. jejuni
Charcoal
Agar
Blood Agar

- Campylobacter jejuni is a spiral shaped, gram-negative, motile bacterium that causes diarrhea in humans.
- It grows best under microaerophilic conditions at 42°C and takes 24-72 hours to culture. Colonies resemble water drops.
- Infection occurs through eating contaminated poultry or untreated water. It releases toxins that destroy gut lining.
- Symptoms include diarrhea, fever, and abdominal pain lasting 5-7 days. Antibiotics like erythromycin or azithromycin can treat severe cases.

![Reference
•Lehman D, Cha H, Shi L. Campylobacter jejuni -
microbewiki [Internet]. Microbewiki.kenyon.edu. 2015
[cited 20 May 2020]. Available from:
https://microbewiki.kenyon.edu/index.php/Campylobacte
r_jejuni
•Wallis M. The Pathogenesis of Campylobacter Jejuni
[Internet]. PubMed. 1994 [cited 20 May 2020]. Available
from: https://pubmed.ncbi.nlm.nih.gov/7841837/](https://image.slidesharecdn.com/campylobacterjejuni-211021003241/85/Campylobacter-jejuni-28-320.jpg)
![Reference
•Javid M. Campylobacter Infections: Background,
Pathophysiology, Epidemiology [Internet].
Emedicine.medscape.com. 2019 [cited 21 May 2020].
Available from:
https://emedicine.medscape.com/article/213720-overview
•Liu L. Campylobacter jejuni - Microbiology - Medbullets
Step 1 [Internet]. Step1.medbullets.com. 2018 [cited 21
May 2020]. Available from:
https://step1.medbullets.com/microbiology/104061/campy
lobacter-jejuni?expandLeftMenu=true](https://image.slidesharecdn.com/campylobacterjejuni-211021003241/85/Campylobacter-jejuni-29-320.jpg)
![Reference
•Campylobacter [Internet]. Who.int. 2020 [cited 21 May
2020]. Available from: https://www.who.int/news-
room/fact-sheets/detail/campylobacter
•Altekruse S, Stern N, Fields P, Swerdlow D.
Campylobacter jejuni—An Emerging Foodborne
Pathogen [Internet]. Center for Disease Control and
Prevention. 1999 [cited 21 May 2020]. Available from:
https://wwwnc.cdc.gov/eid/article/5/1/99-0104_article](https://image.slidesharecdn.com/campylobacterjejuni-211021003241/85/Campylobacter-jejuni-30-320.jpg)
![Reference
• Mims C, Goering R, Dockrell H, Zuckerman M, Chiodini P.
Mims' medical microbiology. 6th ed. New York: Elsevier; 2019.
• Murray P, Rosenthal K, Pfaller M. Medical microbiology. 7th
ed. Philadelphia: Elsevier; 2013.
• Stef L, Cean A, Vasile A, Julean C, Drinceanu D, Corcionivoschi
N. Virulence characteristics of five new Campylobacter jejuni
chicken isolates [Internet]. Gut pathogens. PubMed Central;
2013 [cited 2020May22]. Available from:
https://www.ncbi.nlm.nih.gov/pmc/articles/PMC3866932/#B8](https://image.slidesharecdn.com/campylobacterjejuni-211021003241/85/Campylobacter-jejuni-31-320.jpg)